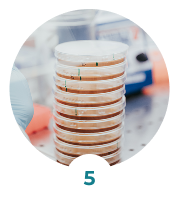

Testez vos produits cosmétiques sur le microbiome : efficacité, innocuité, stabilité !

Le biofilm représente la forme naturelle et protectrice sous laquelle vivent la majorité des bactéries dans leur environnement. Travailler sur le biofilm permet d’évaluer la résistance réelle des bactéries aux traitements, de tester l’effet d’un produit sur une communauté microbienne structurée, et d’anticiper son impact sur l’équilibre du microbiome. C’est aussi indispensable pour simuler des contextes pathologiques chroniques (acné, vaginose, etc.) ou prévenir la formation de biofilms indésirables.

L’étude des bactéries sous forme planctonique (libres) donne une première lecture rapide et ciblée de l’effet d’un actif ou d’une formulation. Cela permet de mesurer l’activité antimicrobienne directe, d’identifier des souches sensibles ou résistantes, et d’orienter les formulations avant de passer à des modèles plus complexes comme le biofilm. Elle complète les analyses biofilm pour une compréhension globale de l’action du produit.


Prise de contact et planification d’un premier rendez-vous

Echange sur vos besoins et présentation de nos expertises

Traduction de vos besoins en plan d’étude par nos experts & validation et lancement du protocole dans notre laboratoire

Echanges réguliers d’état d’avancement du protocole avec nos experts
Présentation et envoie des résultats complets (données brutes, rapport scientifique & marketing d’interprétation et claims obtenus)
Comprendre l’impact de vos produits cosmétiques sur le microbiome est essentiel pour garantir leur innocuité, leur stabilité et leur efficacité. Chez Byome Labs, nous réalisons des analyses approfondies des communautés microbiennes présentes sur la peau, le cuir chevelu, la cavité buccale et la zone intime.
Grâce à notre expertise scientifique, nous vous fournissons des données précises sur l’équilibre du microbiome avant et après l’application de vos produits, vous permettant ainsi d’optimiser vos formulations et d’appuyer vos allégations marketing avec des preuves tangibles.


Notre analyse repose sur une méthodologie scientifique avancée pour garantir des résultats précis et exploitables. Voici les grandes étapes :
Vous désirez prendre rendez-vous ou souhaitez plus d’informations ?
Vous pouvez nous joindre en remplissant le formulaire de contact ci-contre ou par mail à : info@byome-labs.v-labs.fr
BYOME LABS
Cité de l’Innovation
7 rue Auguste Rodin
28630 LE COUDRAY
This site is protected by reCAPTCHA and the Google Privacy Policy and Terms of Service apply.
L’analyse du microbiome humain révèle la complexité des communautés microbiennes qui colonisent notre corps. De nombreuses approches sont utilisées pour l’étude et l’analyse de ce microbiome, allant des techniques de culture aux méthodes de séquençage complexes. Il existe en effet de nombreuses méthodes pour étudier le microbiome, chacune présentant des avantages et des inconvénients, mais apportant des informations complémentaires pour obtenir une vision complète de la communauté microbienne étudiée (1)
L’analyse du microbiome englobe l’ensemble des techniques permettant d’identifier, caractériser et quantifier les micro-organismes présents dans un échantillon microbiologique. Cette discipline combine microbiologie classique, biologie moléculaire, biochimie et bioinformatique pour décrypter la composition et les fonctions des communautés microbiennes (1).
Deux approches principales dominent l’analyse du microbiome : le séquençage génétique qui offre une vision exhaustive de la diversité microbienne, et la culturomique qui permet d’isoler et d’étudier les micro-organismes vivants.
L’ère de la culture classique
Avant l’avènement du séquençage, l’analyse du microbiome reposait exclusivement sur la culture des micro-organismes en laboratoire. Cette approche a permis d’identifier les principales bactéries colonisant la peau : Staphylococcus, Cutibacterium (anciennement Propionibacterium), Corynebacterium, ainsi que des levures comme Malassezia (1,2).
La révolution du séquençage génétique
L’exploration du microbiome a considérablement évolué avec l’essor des technologies de séquençage génétique. Ces avancées ont enrichi notre compréhension de la diversité microbienne et ont permis de caractériser les interactions complexes entre micro-organismes et leur environnement (1,3).
Technologies et approches
Le séquençage offre une vision exhaustive de la diversité microbienne, détectant même les espèces non cultivables. Cette approche reste indispensable pour obtenir une cartographie complète du microbiome (1,4).
Néanmoins, ces méthodes présentent des limitations :
Principe et innovation
Les cultures classiques de bactéries sur boîte de Petri en conditions standards ne sont pas adaptées au développement de nombreuses bactéries, qui nécessitent alors des conditions très précises pour pouvoir se développer.
Face aux limites des cultures traditionnelles, la culturomique a émergé comme une approche pragmatique pour l’analyse du microbiome.
La culturomique multiplie les conditions de culture et utilise des milieux de croissance spécifiques pour favoriser le développement de bactéries exigeantes. L’identification rapide par spectrométrie de masse MALDI-TOF accélère le processus d’analyse.
Diversification des conditions expérimentales
L’analyse du microbiome par culturomique exploite une variété de paramètres :
Cette diversification permet d’isoler des bactéries auparavant considérées comme non cultivables, enrichissant considérablement notre compréhension du microbiome.
La culturomique favorise la croissance de bactéries exigeantes et fournit une meilleure représentation de la diversité microbienne.(3–5)
Expansion du répertoire microbien
Depuis son essor, la culturomique a nettement enrichi la connaissance du microbiome en rendant cultivables de nombreuses espèces auparavant difficiles à étudier. Cette expansion offre de nouvelles perspectives pour l’étude du microbiome et son implication dans diverses pathologies.L’analyse du microbiome devient plus précise et fonctionnelle.
Étude des interactions microbiennes
La culturomique permet de caractériser les micro-organismes en conditions réelles et d’évaluer :
La culture bactérienne reste aujourd’hui indispensable pour approfondir notre connaissance du microbiome cutané. Contrairement aux techniques génomiques qui fournissent une « photographie » des micro-organismes présents, sans distinction entre cellules vivantes et mortes, la culture permet d’isoler des bactéries viables et de les étudier individuellement. Elle offre ainsi des opportunités uniques pour analyser leurs caractéristiques biologiques, leur métabolisme et leur réponse aux traitements/produits.
Synergie séquençage-culturomique
L’analyse du microbiome combine idéalement les deux approches :
Le séquençage fournit une cartographie exhaustive de la diversité microbienne, incluant les espèces non cultivables et a même permis l’identification de nouvelles espèces dans le microbiome. Il révèle le potentiel génétique et métabolique des communautés microbiennes.
La culturomique isole des micro-organismes vivants pour les étudier fonctionnellement. Elle permet de valider les prédictions du séquençage et d’explorer les mécanismes biologiques.
Vers une analyse intégrée
Cette approche intégrée de l’analyse du microbiome offre une vision complète :
Chez BYOME LABS, nous analysons l’impact de vos produits sur les bactéries représentatives du microbiome grâce à la culturomique. Notre approche va jusqu’à l’étude de leur mode de vie en biofilm, reflétant leur état naturel principal sur la peau et les muqueuses.
Notre analyse du microbiome s’appuie sur plus de 20 ans d’expertise cumulée en microbiologie. Les bactéries sélectionnées pour chaque modèle (dysbiose acnéique, dermatite atopique, peau mature, microbiome vaginal, buccal) sont choisies selon les données scientifiques les plus récentes et validées par séquençage génétique.
Cette approche permet d’évaluer l’effet des produits dans des conditions proches de la réalité physiologique et d’obtenir une vision précise du comportement bactérien face à vos formulations.
L’analyse du microbiome continue d’évoluer avec l’émergence de nouvelles technologies. L’intelligence artificielle, la métabolomique et la transcriptomique ouvrent de nouvelles perspectives pour comprendre ces écosystèmes complexes.
Chez BYOME LABS, nous ne plaçons pas une technique au-dessus d’une autre. Nous combinons les forces de chaque approche pour fournir une analyse du microbiome rigoureuse et adaptée aux besoins spécifiques de nos partenaires.
Prêt à analyser l’impact de vos produits sur le microbiome ? Contactez nos experts pour une évaluation personnalisée basée sur la culturomique, et obtenez des résultats exploitables pour vos développements.
Notre site utilise des cookies pour améliorer votre expérience de navigation. En continuant à utiliser notre site, vous acceptez notre utilisation de cookies conformément à notre politique de confidentialité.